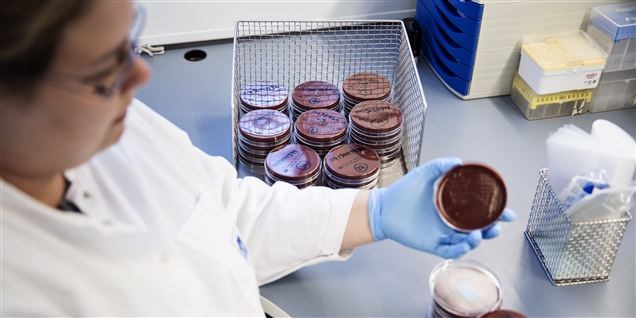

Fra Avisen.dk
Et sjælden enterovirus, der er i familie med polio, har smittet 34 danskere de sidste to år.
Et poliolignende virus, der indtil nu mest har raset i især Kina, er inden for de sidste to år blevet konstateret hos en række små børn i Danmark.
Det viser nye forskningsresultater fra Statens Serum Institut (SSI).
Virusset hedder EV71 C4 og er et såkaldt enterovirus ligesom polio, som nok er den mest kendte type enterovirus. Men mens polio er blevet udryddet i langt det meste af verden på grund af vaccinationer, bliver flere syge af andre typer af enterovirus, skriver SSI fredag.
Læs resten